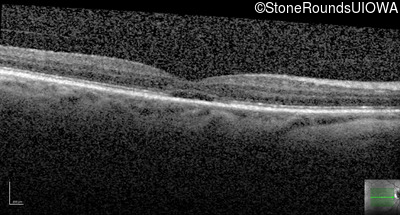
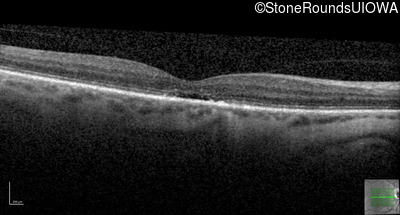
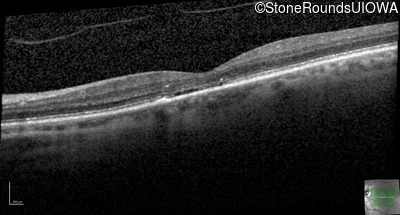
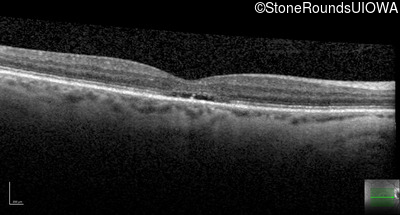
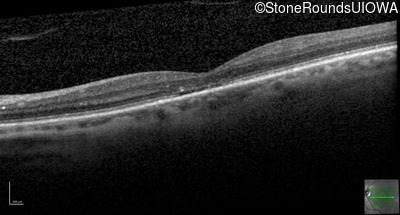
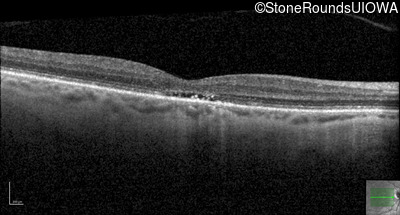
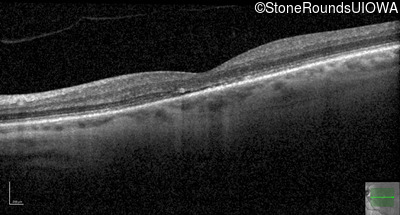

Case
SR2200
Student Mode
Blue Cone Monochromacy (IA2e)
Male
Male
Hidden
SR2200
Student Mode
Blue Cone Monochromacy (IA2e)
Male
Male
History
This 30 year old man has had reduced acuity and abnormal color vision OU since early childhood.
| Color Vision: | Correctly identified the Ishihara control plate but none of the 13 diagnostic plates, OU. |
|---|---|
| Refraction OD: | -2.50 +2.50 x 10 |
| Refraction OS: | -3.00 +2.50 x 5 |
Teaching Points
The clinical features supporting the diagnosis of blue cone monochromacy in this patient include: stable reduced acuity, photophobia and very poor color vision since early childhood, a normal fundus appearance, normally sighted parents and three similarly affected male relatives on the maternal side of his family.
| Age at visit: 55 years |
Diagnosis & molecular findings
| Disease | Gene | Allele 1 variant(s) | Allele 2 variant(s) | Inheritance mode |
|---|---|---|---|---|
| Blue Cone Monochromacy | L/M OPSIN Cluster | Deletion of LW opsin genes + Gly204Ser GGC>AGC in single MW opsin gene | XL |
Disease:
Gene:
Allele 1:
Deletion of LW opsin genes + Gly204Ser GGC>AGC in single MW opsin gene
Allele 2:
Inheritance:
XL